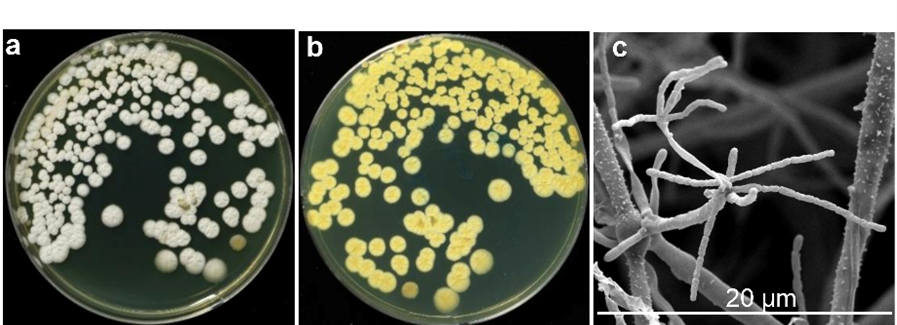

TS. Nguyễn Thị Thanh Loan

Họ và tên: TS. Nguyễn Thị Thanh Loan
Số lượng công bố (WoS): 5
H-index (theo WoS): 3
Mail: nguyenthithanhloan@tdtu.edu.vn
- Hướng nghiên cứu chính: Phát triển bền vững Tài nguyên và Môi trường
* Biological control

* Microbiology
* Natural Products

* Plant Biotechnology

- Công bố tiêu biểu (5 bài):
- Loan Thi Thanh Nguyen, Ae Ran Park, Hye Won Im, Ve Van Le, Yu Jeong Yeo, Hang Thi Thu Nguyen, Quang Le Dang, Tran Thi Nhu Hoa, Ha Hang Le, Van Thi Nguyen, Inmin Hwang, Jin-Cheol Kim (2025). Biological control of tomato bacterial wilt and apple fire blight via induced resistance by azomycin from Streptomyces JCK-8368. Front Plant Sci, 16, p.1654826.
- Hoang Chau Le, Hai Dang Le, Thi Dung Tran, Loan Thi Thanh Nguyen, Hang T.T. Nguyen (2025). Optimization of saponin extraction extract from red sage (Salvia militorrhiza) roots using response surface methods and its biological activities. Process, 13(7), p.2225.
- Ve Van Le, So-Ra Ko, Loan Thi Thanh Nguyen, Jin-Cheol Kim, Yuna Shin, Kyunghyun Kim, Chi-Yong Ahn (2024). Undibacterium cyanobacteriorum nov., an auxin-producing bacterium isolated from fresh water during cyanobacterial bloom period. Antonie van Leeuwenhoek, 117(1), p.99.
- Loan Thi Thanh Nguyen, Ae Ran Park, Ve Van Le, Inmin Hwang, Jin-Cheol Kim (2024). Exploration of a multifunctional biocontrol agent Streptomyces JCK-8055 for the management of apple fire blight. Appl Microbiol and Biotechnol, 108(1), p.49.
- Loan Thi Thanh Nguyen, JaYeong Jang, Tae Yoon Kim, Nan Hee Yu, Ae-Ran Park, Won Jae Chi, Chang-Hwan Bae, Joo Hong Yeo, HaeWoong Park, Jin-Cheol Kim (2018). Nematicidal Activity of Macrocyclic Trichothecine from Myrothecium verrucaria against Meloidogyne incognita. Pestic Biochem Physiol, 148, pp.133-143.
- Đề tài/dự án đã chủ trì/tham gia (số lượng):
- Đào tạo thành công Tiến sĩ/Thạc sĩ …:
- Sản phẩm khoa học/ chuyển giao công nghệ tiêu biểu (bằng sáng chế, giải pháp hữu ích):
- Bằng sáng chế số PN230235 “Composition for controlling plant disease or enhancing plant-induced resistance containing Streptomyces JCK-8368 strain, culture or fraction thereof, method for producing the same, and method for controlling plant disease or enhancing plant-induced resistance using the same”. Các tác giả: Kim Jin-Cheol, Nguyễn Thị Thanh Loan, Park Ae Ran, Yu Nan Hee.
- Bằng sáng chế số PN220374” Composition for controlling plant diseases comprising culture solution of Streptomyces JCK-8055 strain or extract thereof, method for manufacturing the same and method for controlling using the same.” Các tác giả: Kim Jin-Cheol, Park Ae Ran, Nguyễn Thị Thanh Loan.
- Các thành tích khác (ban biên tập tạp chí/ giải thưởng ….):
- Log in to post comments
